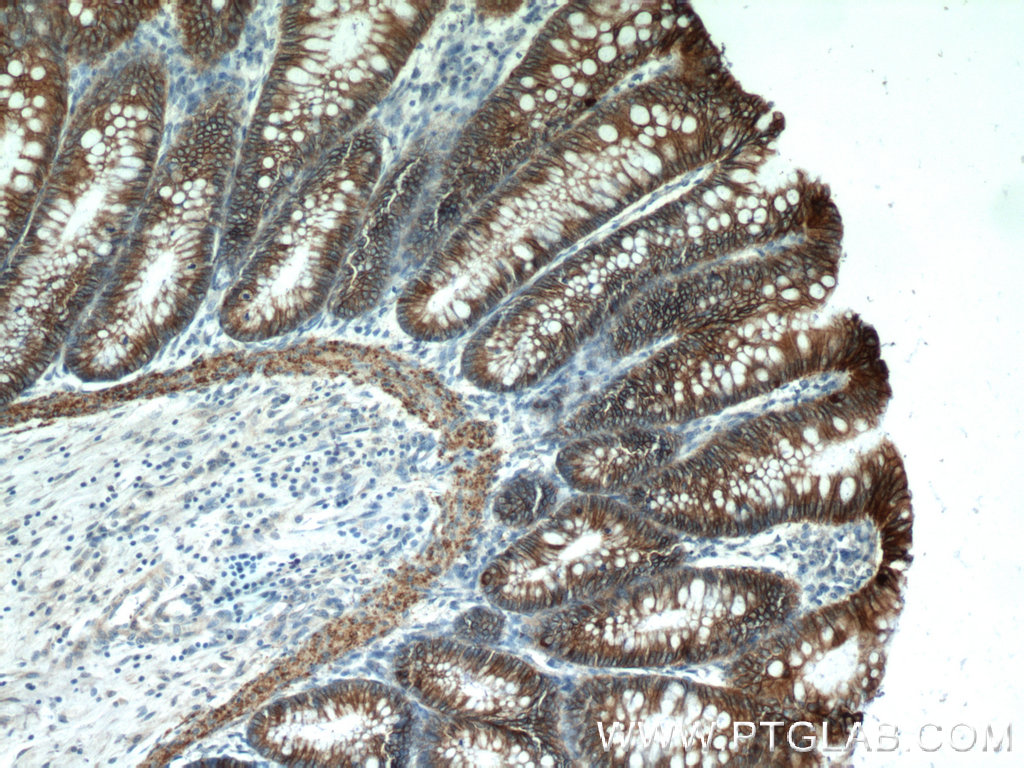
Cadherin17 Antibody 243391AP Proteintech

Cadherin-17 is a protein that in humans is encoded by the CDH17 gene.
This gene is a member of the cadherin superfamily, genes encoding calcium-dependent, membrane-associated glycoproteins. The encoded protein is cadherin-like, consisting of an extracellular region, containing 7 cadherin domains, and a transmembrane region but lacking the conserved cytoplasmic domain. The protein is a component of the gastrointestinal tract and pancreatic ducts, acting as an intestinal proton-dependent peptide transporter in the first step in oral absorption of many medically important peptide-based drugs. The protein may also play a role in the morphological organization of liver and intestine.
References
Further reading
External links
- CDH17 human gene location in the UCSC Genome Browser.
- CDH17 human gene details in the UCSC Genome Browser.
- Human CDH16 genome location and CDH16 gene details page in the UCSC Genome Browser.